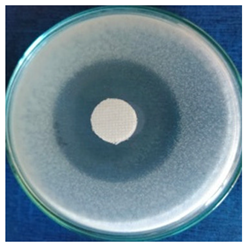
Materials 16 03924 i001
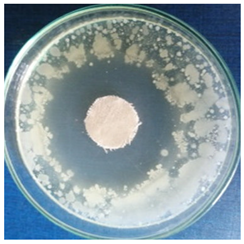
Materials 16 03924 i008

Phytochemical Synthesis of Silver Nanoparticles and Their Antimicrobial Investigation on Cotton and Wool Textiles
Abstract
1. Introduction
2. Materials and Methods
2.1. Materials
2.2. Characterization of Stellaria Media Extract
2.3. Synthesis, Optimization Strategies, and Physico-Chemical Characterization of Green Silver Nanoparticles
2.4. Textiles Treatment and Characterization
3. Results and Discussions
3.1. Characterization of the Plant Extract and Spectral Optimization of the AgNPs Dispersions
3.2. Size and Polydispersity Optimization of the AgNPs Dispersions
3.3. Physical Stability of the AgNPs Dispersions
3.4. In Vitro Antioxidant Activity and Phenolic Content Assessment
3.4.1. Chemiluminescence Assay
3.4.2. TEAC Method
3.4.3. Phenolic Content Assessment
3.5. Silver Nanoparticles Characterization
3.6. Characterization of the Treated Textile Samples
3.6.1. Morphological Characterization of the Treated Textile Samples
3.6.2. Chromatic Parameters of the Treated Textile Samples
3.6.3. Antimicrobial Activity Assessment
4. Conclusions
Supplementary Materials
Author Contributions
Funding
Institutional Review Board Statement
Informed Consent Statement
Data Availability Statement
Conflicts of Interest
References
- Doughty, A.; Hoover, A.; Layton, E.; Murray, C.; Howard, E.; Chen, W. Nanomaterial Applications in Photothermal Therapy for Cancer. Materials 2019, 12, 779. [Google Scholar] [CrossRef]
- Yang, Y.; Zhang, C.; Lai, C.; Zeng, G.; Huang, D.; Cheng, M.; Wang, J.; Chen, F.; Zhou, C.; Xiong, W. BiOX (X = Cl, Br, I) Photocatalytic Nanomaterials: Applications for Fuels and Environmental Management. Adv. Colloid Interface Sci. 2018, 254, 76–93. [Google Scholar] [CrossRef] [PubMed]
- Kumar, L.; Bharadvaja, N. Biosynthesis, Characterization, and Evaluation of Antibacterial and Photocatalytic Dye Degradation Activities of Silver Nanoparticles Biosynthesized by Chlorella Sorokiniana. Biomass Convers. Biorefin. 2022. [Google Scholar] [CrossRef]
- Rohilla, D.; Chaudhary, S.; Umar, A. An Overview of Advanced Nanomaterials for Sensor Applications. Eng. Sci. 2021, 16, 47–70. [Google Scholar] [CrossRef]
- Malhotra, B.D.; Ali, M.A. Nanomaterials in Biosensors. In Nanomaterials for Biosensors; Elsevier: Amsterdam, The Netherlands, 2018; pp. 1–74. [Google Scholar]
- Yu, J.; Luo, M.; Lv, Z.; Huang, S.; Hsu, H.-H.; Kuo, C.-C.; Han, S.-T.; Zhou, Y. Recent Advances in Optical and Optoelectronic Data Storage Based on Luminescent Nanomaterials. Nanoscale 2020, 12, 23391–23423. [Google Scholar] [CrossRef]
- Deshmukh, S.P.; Patil, S.M.; Mullani, S.B.; Delekar, S.D. Silver Nanoparticles as an Effective Disinfectant: A Review. Mater. Sci. Eng. C 2019, 97, 954–965. [Google Scholar] [CrossRef]
- Panáček, A.; Kvítek, L.; Prucek, R.; Kolář, M.; Večeřová, R.; Pizúrová, N.; Sharma, V.K.; Nevěčná, T.; Zbořil, R. Silver Colloid Nanoparticles: Synthesis, Characterization, and Their Antibacterial Activity. J. Phys. Chem. B 2006, 110, 16248–16253. [Google Scholar] [CrossRef]
- Bruna, T.; Maldonado-Bravo, F.; Jara, P.; Caro, N. Silver Nanoparticles and Their Antibacterial Applications. Int. J. Mol. Sci. 2021, 22, 7202. [Google Scholar] [CrossRef]
- Devatha, C.P.; Thalla, A.K. Green Synthesis of Nanomaterials. In Synthesis of Inorganic Nanomaterials; Elsevier: Amsterdam, The Netherlands, 2018; pp. 169–184. [Google Scholar]
- Sintubin, L.; Verstraete, W.; Boon, N. Biologically Produced Nanosilver: Current State and Future Perspectives. Biotechnol. Bioeng. 2012, 109, 2422–2436. [Google Scholar] [CrossRef]
- Barbinta-Patrascu, M.E.; Badea, N.; Ungureanu, C.; Iordache, S.M.; Constantin, M.; Purcar, V.; Rau, I.; Pirvu, C. Ecobiophysical Aspects on Nanosilver Biogenerated from Citrus Reticulata Peels, as Potential Biopesticide for Controlling Pathogens and Wetland Plants in Aquatic Media. J. Nanomater. 2017, 2017, 4214017. [Google Scholar] [CrossRef]
- Barbinta-Patrascu, M.E.; Badea, N.; Ungureanu, C.; Constantin, M.; Pirvu, C.; Rau, I. Silver-Based Biohybrids “Green” Synthesized from Chelidonium majus L. Opt. Mater. 2016, 56, 94–99. [Google Scholar] [CrossRef]
- Barbinta-Patrascu, M.E.; Badea, N.; Bacalum, M.; Ungureanu, C.; Suica-Bunghez, I.R.; Iordache, S.M.; Pirvu, C.; Zgura, I.; Maraloiu, V.A. 3D Hybrid Structures Based on Biomimetic Membranes and Caryophyllus Aromaticus—“Green” Synthesized Nano-Silver with Improved Bioperformances. Mater. Sci. Eng. C 2019, 101, 120–137. [Google Scholar] [CrossRef] [PubMed]
- Roy, A.; Bulut, O.; Some, S.; Mandal, A.K.; Yilmaz, M.D. Green Synthesis of Silver Nanoparticles: Biomolecule-Nanoparticle Organizations Targeting Antimicrobial Activity. RSC Adv. 2019, 9, 2673–2702. [Google Scholar] [CrossRef]
- Shahid-ul-Islam; Butola, B.S.; Kumar, A. Green Chemistry Based In-Situ Synthesis of Silver Nanoparticles for Multifunctional Finishing of Chitosan Polysaccharide Modified Cellulosic Textile Substrate. Int. J. Biol. Macromol. 2020, 152, 1135–1145. [Google Scholar] [CrossRef]
- Kanniah, P.; Chelliah, P.; Thangapandi, J.R.; Gnanadhas, G.; Mahendran, V.; Robert, M. Green Synthesis of Antibacterial and Cytotoxic Silver Nanoparticles by Piper Nigrum Seed Extract and Development of Antibacterial Silver Based Chitosan Nanocomposite. Int. J. Biol. Macromol. 2021, 189, 18–33. [Google Scholar] [CrossRef] [PubMed]
- Maghimaa, M.; Alharbi, S.A. Green Synthesis of Silver Nanoparticles from Curcuma Longa L. and Coating on the Cotton Fabrics for Antimicrobial Applications and Wound Healing Activity. J. Photochem. Photobiol. B 2020, 204, 111806. [Google Scholar] [CrossRef]
- Veeraraghavan, V.P.; Periadurai, N.D.; Karunakaran, T.; Hussain, S.; Surapaneni, K.M.; Jiao, X. Green Synthesis of Silver Nanoparticles from Aqueous Extract of Scutellaria Barbata and Coating on the Cotton Fabric for Antimicrobial Applications and Wound Healing Activity in Fibroblast Cells (L929). Saudi J. Biol. Sci. 2021, 28, 3633–3640. [Google Scholar] [CrossRef] [PubMed]
- Rajput, D.; Paul, S.; Gupta, A. Green Synthesis of Silver Nanoparticles Using Waste Tea Leaves. Adv. Nano Res. 2020, 3, 1–14. [Google Scholar] [CrossRef]
- Kabeerdass, N.; Murugesan, K.; Arumugam, N.; Almansour, A.I.; Kumar, R.S.; Djearamane, S.; Kumaravel, A.K.; Velmurugan, P.; Mohanavel, V.; Kumar, S.S.; et al. Biomedical and Textile Applications of Alternanthera Sessilis Leaf Extract Mediated Synthesis of Colloidal Silver Nanoparticle. Nanomaterials 2022, 12, 2759. [Google Scholar] [CrossRef]
- Eid, A.M.; Fouda, A.; Niedbała, G.; Hassan, S.E.-D.; Salem, S.S.; Abdo, A.M.; Hetta, H.F.; Shaheen, T.I. Endophytic Streptomyces Laurentii Mediated Green Synthesis of Ag-NPs with Antibacterial and Anticancer Properties for Developing Functional Textile Fabric Properties. Antibiotics 2020, 9, 641. [Google Scholar] [CrossRef]
- Lite, M.C.; Constantinescu, R.R.; Tanasescu, E.C.; Iordache, O.G.; Badea, N. Textile Artefacts Conservation Using Nanomaterials—Review. Ind. Text. 2022, 73, 607–613. [Google Scholar] [CrossRef]
- Becerra, J.; Mateo, M.; Ortiz, P.; Nicolás, G.; Zaderenko, A.P. Evaluation of the Applicability of Nano-Biocide Treatments on Limestones Used in Cultural Heritage. J. Cult. Herit. 2019, 38, 126–135. [Google Scholar] [CrossRef]
- Fouda, A.; Abdel-Maksoud, G.; Abdel-Rahman, M.A.; Salem, S.S.; Hassan, S.E.-D.; El-Sadany, M.A.-H. Eco-Friendly Approach Utilizing Green Synthesized Nanoparticles for Paper Conservation against Microbes Involved in Biodeterioration of Archaeological Manuscript. Int. Biodeterior. Biodegrad. 2019, 142, 160–169. [Google Scholar] [CrossRef]
- Pietrzak, K.; Otlewska, A.; Danielewicz, D.; Dybka, K.; Pangallo, D.; Kraková, L.; Puškárová, A.; Bučková, M.; Scholtz, V.; Ďurovič, M.; et al. Disinfection of Archival Documents Using Thyme Essential Oil, Silver Nanoparticles Misting and Low Temperature Plasma. J. Cult. Herit. 2017, 24, 69–77. [Google Scholar] [CrossRef]
- Saada, N.S.; Abdel-Maksoud, G.; Abd El-Aziz, M.S.; Youssef, A.M. Green Synthesis of Silver Nanoparticles, Characterization, and Use for Sustainable Preservation of Historical Parchment against Microbial Biodegradation. Biocatal. Agric. Biotechnol. 2021, 32, 101948. [Google Scholar] [CrossRef]
- Oladeji, O.S.; Oyebamiji, A.K. Stellaria Media (L.) Vill.—A Plant with Immense Therapeutic Potentials: Phytochemistry and Pharmacology. Heliyon 2020, 6, e04150. [Google Scholar] [CrossRef]
- Rogowska, M.; Lenart, M.; Srečec, S.; Ziaja, M.; Parzonko, A.; Bazylko, A. Chemical Composition, Antioxidative and Enzyme Inhibition Activities of Chickweed Herb (Stelaria media L., Vill.) Ethanolic and Aqueous Extracts. Ind. Crops Prod. 2017, 97, 448–454. [Google Scholar] [CrossRef]
- Miere, F.G.; Ganea, M.; Teodorescu, A.G.; Fritea, L.; Lestyan, M.; Horvath, T.; Hanga-Fărcaș, A.; Vicaș, S.I. The Green Synthesıs of Sılver and Selenıum Nanopartıcles Usıng the Plant Stellarıa Medıa (L.) Vıll. Pharmacophore 2022, 13, 88–95. [Google Scholar] [CrossRef]
- Lite, M.C.; Constantinescu, R.R.; Tănăsescu, E.C.; Kuncser, A.; Romanițan, C.; Lăcătuşu, I.; Badea, N. Design of Green Silver Nanoparticles Based on Primula Officinalis Extract for Textile Preservation. Materials 2022, 15, 7695. [Google Scholar] [CrossRef]
- Smitha, S.L.; Nissamudeen, K.M.; Philip, D.; Gopchandran, K.G. Studies on Surface Plasmon Resonance and Photoluminescence of Silver Nanoparticles. Spectrochim. Acta A Mol. Biomol. Spectrosc. 2008, 71, 186–190. [Google Scholar] [CrossRef]
- Lacatusu, I.; Badea, N.; Badea, G.; Brasoveanu, L.; Stan, R.; Ott, C.; Oprea, O.; Meghea, A. Ivy Leaves Extract Based – Lipid Nanocarriers and Their Bioefficacy on Antioxidant and Antitumor Activities. RSC Adv. 2016, 6, 77243–77255. [Google Scholar] [CrossRef]
- ISO 14502-1; Determination of Substances Characteristic of Green and Black Tea, Part 1: Content of Total Polyphenols in Tea—Colorimetric Method Using Folin-Ciocalteu Reagent. 1st ed, International Organization for Standardization: Geneva, Switzerland, 2005.
- Ingamells, W. ; Society of Dyers and Colourists. Colour for Textiles: A User’s Handbook; Society of Dyers and Colourists: Bradford, UK, 1993; ISBN 0901956562. [Google Scholar]
- ISO 20743-1; Textiles—Determination of Antibacterial Activity of Antibacterial Finished Products. International Organization for Standardization: Geneva, Switzerland, 2007.
- Valgas, C.; de Souza, S.M.; Smânia, E.F.A.; Smânia, A., Jr. Screening Methods to Determine Antibacterial Activity of Natural Products. Braz. J. Microbiol. 2007, 38, 369–380. [Google Scholar] [CrossRef]
- Barbinta-Patrascu, M.E.; Ungureanu, C.; Iordache, S.M.; Iordache, A.M.; Bunghez, I.-R.; Ghiurea, M.; Badea, N.; Fierascu, R.-C.; Stamatin, I. Eco-Designed Biohybrids Based on Liposomes, Mint–Nanosilver and Carbon Nanotubes for Antioxidant and Antimicrobial Coating. Mater. Sci. Eng. C 2014, 39, 177–185. [Google Scholar] [CrossRef] [PubMed]
- Chak, P.; Chaudhary, D.; Jain, S.; Soni, P.S.; Jain, P.K.; Dwivedi, J.; Sharma, S. Phytochemical and Gas Chromatography-Mass Spectrometry Analysis of Chenopodium Album and Stellaria Media. Indian J. Pharm. Sci. 2021, 83, 881. [Google Scholar] [CrossRef]
- Gruz, J.; Novák, O.; Strnad, M. Rapid Analysis of Phenolic Acids in Beverages by UPLC–MS/MS. Food Chem. 2008, 111, 789–794. [Google Scholar] [CrossRef]
- Ahmed, R.H.; Mustafa, D.E. Green Synthesis of Silver Nanoparticles Mediated by Traditionally Used Medicinal Plants in Sudan. Int. Nano Lett. 2020, 10, 1–14. [Google Scholar] [CrossRef]
- Gomathi, M.; Prakasam, A.; Rajkumar, P.V.; Rajeshkumar, S.; Chandrasekaran, R.; Anbarasan, P.M. Green Synthesis of Silver Nanoparticles Using Gymnema Sylvestre Leaf Extract and Evaluation of Its Antibacterial Activity. S. Afr. J. Chem. Eng. 2020, 32, 1–4. [Google Scholar] [CrossRef]
- Hasan Jabbar, A.; Hamzah, M.Q.; Mezan, S.O.; Tuama, A.N.; Shkhair, H.; Al-Janabi, O.; Tumah, A.N.; Saryati, A.; Ameruddin, B.; Agam, A. Green Synthesis and Characterization of Silver Nanoparticle (AgNPs) Using Pandanus Atrocarpus Extract. Int. J. Adv. Sci. Technol. 2020, 29, 4913–4922. [Google Scholar]
- Ghaffari-Moghaddam, M.; Hadi-Dabanlou, R.; Khajeh, M.; Rakhshanipour, M.; Shameli, K. Green Synthesis of Silver Nanoparticles Using Plant Extracts. Korean J. Chem. Eng. 2014, 31, 548–557. [Google Scholar] [CrossRef]
- Ahmed, S.; Ahmad, M.; Swami, B.L.; Ikram, S. A Review on Plants Extract Mediated Synthesis of Silver Nanoparticles for Antimicrobial Applications: A Green Expertise. J. Adv. Res. 2016, 7, 17–28. [Google Scholar] [CrossRef]
- Manosalva, N.; Tortella, G.; Cristina Diez, M.; Schalchli, H.; Seabra, A.B.; Durán, N.; Rubilar, O. Green Synthesis of Silver Nanoparticles: Effect of Synthesis Reaction Parameters on Antimicrobial Activity. World J. Microbiol. Biotechnol. 2019, 35, 88. [Google Scholar] [CrossRef]
- Barbinta-Patrascu, M.E.; Ungureanu, C.; Badea, N.; Bacalum, M.; Lazea-Stoyanova, A.; Zgura, I.; Negrila, C.; Enculescu, M.; Burnei, C. Novel Ecogenic Plasmonic Biohybrids as Multifunctional Bioactive Coatings. Coatings 2020, 10, 659. [Google Scholar] [CrossRef]
- Michalak, M. Plant-Derived Antioxidants: Significance in Skin Health and the Ageing Process. Int. J. Mol. Sci. 2022, 23, 585. [Google Scholar] [CrossRef] [PubMed]
- Csakvari, A.C.; Moisa, C.; Radu, D.G.; Olariu, L.M.; Lupitu, A.I.; Panda, A.O.; Pop, G.; Chambre, D.; Socoliuc, V.; Copolovici, L.; et al. Green Synthesis, Characterization, and Antibacterial Properties of Silver Nanoparticles Obtained by Using Diverse Varieties of Cannabis Sativa Leaf Extracts. Molecules 2021, 26, 4041. [Google Scholar] [CrossRef] [PubMed]
- Balciunaitiene, A.; Viskelis, P.; Viskelis, J.; Streimikyte, P.; Liaudanskas, M.; Bartkiene, E.; Zavistanaviciute, P.; Zokaityte, E.; Starkute, V.; Ruzauskas, M.; et al. Green Synthesis of Silver Nanoparticles Using Extract of Artemisia absinthium L., Humulus lupulus L. and Thymus vulgaris L., Physico-Chemical Characterization, Antimicrobial and Antioxidant Activity. Processes 2021, 9, 1304. [Google Scholar] [CrossRef]
- Bedlovičová, Z.; Strapáč, I.; Baláž, M.; Salayová, A. A Brief Overview on Antioxidant Activity Determination of Silver Nanoparticles. Molecules 2020, 25, 3191. [Google Scholar] [CrossRef]
- Djeridane, A.; Yousfi, M.; Nadjemi, B.; Boutassouna, D.; Stocker, P.; Vidal, N. Antioxidant Activity of Some Algerian Medicinal Plants Extracts Containing Phenolic Compounds. Food Chem. 2006, 97, 654–660. [Google Scholar] [CrossRef]
- Rajurkar, N.; Hande, S. Estimation of Phytochemical Content and Antioxidant Activity of Some Selected Traditional Indian Medicinal Plants. Indian J. Pharm. Sci. 2011, 73, 146. [Google Scholar] [CrossRef]
- Venkatadri, B.; Shanparvish, E.; Rameshkumar, M.R.; Arasu, M.V.; Al-Dhabi, N.A.; Ponnusamy, V.K.; Agastian, P. Green Synthesis of Silver Nanoparticles Using Aqueous Rhizome Extract of Zingiber Officinale and Curcuma Longa: In-Vitro Anti-Cancer Potential on Human Colon Carcinoma HT-29 Cells. Saudi J. Biol. Sci. 2020, 27, 2980–2986. [Google Scholar] [CrossRef]
- Mosallam, F.M.; El-Sayyad, G.S.; Fathy, R.M.; El-Batal, A.I. Biomolecules-Mediated Synthesis of Selenium Nanoparticles Using Aspergillus Oryzae Fermented Lupin Extract and Gamma Radiation for Hindering the Growth of Some Multidrug-Resistant Bacteria and Pathogenic Fungi. Microb. Pathog 2018, 122, 108–116. [Google Scholar] [CrossRef]
- Kambale, E.K.; Nkanga, C.I.; Mutonkole, B.-P.I.; Bapolisi, A.M.; Tassa, D.O.; Liesse, J.-M.I.; Krause, R.W.M.; Memvanga, P.B. Green Synthesis of Antimicrobial Silver Nanoparticles Using Aqueous Leaf Extracts from Three Congolese Plant Species (Brillantaisia Patula, Crossopteryx Febrifuga and Senna Siamea). Heliyon 2020, 6, e04493. [Google Scholar] [CrossRef] [PubMed]
- Sarwer, Q.; Amjad, M.S.; Mehmood, A.; Binish, Z.; Mustafa, G.; Farooq, A.; Qaseem, M.F.; Abasi, F.; Pérez de la Lastra, J.M. Green Synthesis and Characterization of Silver Nanoparticles Using Myrsine Africana Leaf Extract for Their Antibacterial, Antioxidant and Phytotoxic Activities. Molecules 2022, 27, 7612. [Google Scholar] [CrossRef] [PubMed]
- Barbinta-Patrascu, M.E.; Nichita, C.; Badea, N.; Ungureanu, C.; Bacalum, M.; Zgura, I.; Iosif, L.; Antohe, S. Biophysical aspects of bio-nanosilver generated from urtica dioica leaves and vitis vinifera fruits’ extracts. Rom. Rep. Phys. 2021, 73, 601. [Google Scholar]
- Ibrahim, H.M.; Zaghloul, S.; Hashem, M.; El-Shafei, A. A Green Approach to Improve the Antibacterial Properties of Cellulose Based Fabrics Using Moringa Oleifera Extract in Presence of Silver Nanoparticles. Cellulose 2021, 28, 549–564. [Google Scholar] [CrossRef]
- Rodrigues, A.G.; Romano de Oliveira Gonçalves, P.J.; Ottoni, C.A.; de Cássia Ruiz, R.; Morgano, M.A.; de Araújo, W.L.; de Melo, I.S.; De Souza, A.O. Functional Textiles Impregnated with Biogenic Silver Nanoparticles from Bionectria Ochroleuca and Its Antimicrobial Activity. Biomed. Microdevices 2019, 21, 56. [Google Scholar] [CrossRef]
- Ibrahim, H.M.M.; Hassan, M.S. Characterization and Antimicrobial Properties of Cotton Fabric Loaded with Green Synthesized Silver Nanoparticles. Carbohydr. Polym. 2016, 151, 841–850. [Google Scholar] [CrossRef]
- Mahmud, S.; Pervez, M.N.; Sultana, M.Z.; Habib, M.A.; Liu, H.-H. Wool Functionalization by Using Green Synthesized Silver Nanoparticles. Orient. J. Chem. 2017, 33, 2198–2208. [Google Scholar] [CrossRef]
- Kelly, F.M.; Johnston, J.H. Colored and Functional Silver Nanoparticle−Wool Fiber Composites. ACS Appl. Mater. Interfaces 2011, 3, 1083–1092. [Google Scholar] [CrossRef]
- Syafiuddin, A. Toward a Comprehensive Understanding of Textiles Functionalized with Silver Nanoparticles. J. Chin. Chem. Soc. 2019, 66, 793–814. [Google Scholar] [CrossRef]
- Pietrzak, K.; Gutarowska, B.; Machnowski, W.; Mikołajczyk, U. Antimicrobial Properties of Silver Nanoparticles Misting on Cotton Fabrics. Text. Res. J. 2016, 86, 812–822. [Google Scholar] [CrossRef]
- Mabdelghaffar, F.; Mahmoud, M.G.; Asker, M.S.; Mohamed, S.S. Facile Green Silver Nanoparticles Synthesis to Promote the Antibacterial Activity of Cellulosic Fabric. J. Ind. Eng. Chem. 2021, 99, 224–234. [Google Scholar] [CrossRef]
- Mansoor, S.; Zahoor, I.; Baba, T.R.; Padder, S.A.; Bhat, Z.A.; Koul, A.M.; Jiang, L. Fabrication of Silver Nanoparticles Against Fungal Pathogens. Front. Nanotechnol. 2021, 3, 358. [Google Scholar] [CrossRef]
- Kim, K.-J.; Sung, W.S.; Suh, B.K.; Moon, S.-K.; Choi, J.-S.; Kim, J.G.; Lee, D.G. Antifungal Activity and Mode of Action of Silver Nano-Particles on Candida Albicans. BioMetals 2009, 22, 235–242. [Google Scholar] [CrossRef] [PubMed]
- Salem, S.S.; EL-Belely, E.F.; Niedbała, G.; Alnoman, M.M.; Hassan, S.E.-D.; Eid, A.M.; Shaheen, T.I.; Elkelish, A.; Fouda, A. Bactericidal and In-Vitro Cytotoxic Efficacy of Silver Nanoparticles (Ag-NPs) Fabricated by Endophytic Actinomycetes and Their Use as Coating for the Textile Fabrics. Nanomaterials 2020, 10, 2082. [Google Scholar] [CrossRef]















| Compound | Molecular Formula | Calculated Mass (m/z) | Measured Mass (m/z) | Mass Accuracy (ppm) | |||
|---|---|---|---|---|---|---|---|
| ESI+ | ESI- | ESI+ | ESI- | ESI+ | ESI- | ||
| Apigenin-7-O-neohesperidoside (Rhoifolin) | C27H30O14 | 579.170832 | - | 579.170618 | - | −0.369494 | - |
| Apigenin-6,8-di-C-glucoside | C27H30O15 | 595.165747 | 593.151194 | 595.165468 | 593.149057 | −0.468777 | −3.602791 |
| Apigenin-6-Arabinosyl-8-galactosyl | C26H28O14 | 565.155182 | 563.140629 | 565.154995 | 563.140115 | −0.330883 | −0.912738 |
| Apigenin-6-C-glucoside (Isovitexin) | C21H20O10 | 433.112923 | - | 433.112951 | - | 0.064648 | - |
| Vanillic acid glucoside | C14H18O9Na | 353.084303 | - | 353.083926 | - | −1.067734 | - |
| Caffeoylquinic acid | C16H18O9 | - | 353.087806 | - | 353.087272 | - | −1.512372 |
| Hydroxybenzoic acid | C7H6O3 | - | 137.024418 | - | 137.024409 | - | −0.065682 |
| Ellagic acid | C14H6O8 | 303.013544 | - | 303.014468 | - | 3.049369 | - |
| Sample | L* | a* | b* | ∆L* | ∆a* | ∆b* | ∆E* | |
|---|---|---|---|---|---|---|---|---|
| Untreated cotton | 93.48 | −0.27 | 3.83 | - | - | - | - | |
| Untreated wool | 83.96 | −0.19 | 10.17 | - | - | - | - | |
| AgNPs | Cotton | 87.35 | 1.40 | 7.49 | −6.12 | 1.67 | 3.66 | 7.33 |
| Wool | 77.91 | 0.84 | 8.01 | −6.05 | 1.02 | −2.15 | 6.50 | |
| Bacterial Strain | Textile Sample | CFUs/mL on Control Samples | CFUs/mL on Samples Treated with AgNPs Dispersions | Bactericidal Ratio (%) |
|---|---|---|---|---|
| Escherichia coli | Cotton | 2.1 × 104 | 0 | 100 |
| Wool | 2.8 × 104 | 0 | 100 | |
| Saphylococcus aureus | Cotton | 4.5 × 104 | 4 | 99.99 |
| Wool | 5.5 × 104 | 6 | 99.99 | |
| Bacillus subtilis | Cotton | 2.9 × 104 | 0 | 100 |
| Wool | 3.7 × 104 | 2 | 99.99 |
| Textile Sample | Cotton | Wool |
|---|---|---|
| Microbial Strain | ||
| Escherichia coli | |  |
| Saphylococcus aureus |  |  |
| Bacillus subtilis |  |  |
| Penicillium hirsutum |  | |
Disclaimer/Publisher’s Note: The statements, opinions and data contained in all publications are solely those of the individual author(s) and contributor(s) and not of MDPI and/or the editor(s). MDPI and/or the editor(s) disclaim responsibility for any injury to people or property resulting from any ideas, methods, instructions or products referred to in the content. |
© 2023 by the authors. Licensee MDPI, Basel, Switzerland. This article is an open access article distributed under the terms and conditions of the Creative Commons Attribution (CC BY) license (https://creativecommons.org/licenses/by/4.0/).
Share and Cite
Lite, M.C.; Constantinescu, R.; Tănăsescu, E.C.; Kuncser, A.; Romanițan, C.; Mihaiescu, D.E.; Lacatusu, I.; Badea, N. Phytochemical Synthesis of Silver Nanoparticles and Their Antimicrobial Investigation on Cotton and Wool Textiles. Materials 2023, 16, 3924. https://doi.org/10.3390/ma16113924
Lite MC, Constantinescu R, Tănăsescu EC, Kuncser A, Romanițan C, Mihaiescu DE, Lacatusu I, Badea N. Phytochemical Synthesis of Silver Nanoparticles and Their Antimicrobial Investigation on Cotton and Wool Textiles. Materials. 2023; 16(11):3924. https://doi.org/10.3390/ma16113924
Chicago/Turabian StyleLite, Mihaela Cristina, Roxana Constantinescu, Elena Cornelia Tănăsescu, Andrei Kuncser, Cosmin Romanițan, Dan Eduard Mihaiescu, Ioana Lacatusu, and Nicoleta Badea. 2023. "Phytochemical Synthesis of Silver Nanoparticles and Their Antimicrobial Investigation on Cotton and Wool Textiles" Materials 16, no. 11: 3924. https://doi.org/10.3390/ma16113924
APA StyleLite, M. C., Constantinescu, R., Tănăsescu, E. C., Kuncser, A., Romanițan, C., Mihaiescu, D. E., Lacatusu, I., & Badea, N. (2023). Phytochemical Synthesis of Silver Nanoparticles and Their Antimicrobial Investigation on Cotton and Wool Textiles. Materials, 16(11), 3924. https://doi.org/10.3390/ma16113924










